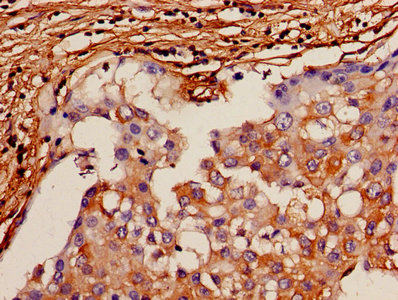

APLN Antibody
-
中文名稱:APLN兔多克隆抗體
-
貨號:CSB-PA001909OJ01HU
-
規(guī)格:¥440
-
圖片:
-
其他:
產(chǎn)品詳情
-
產(chǎn)品名稱:Rabbit anti-Homo sapiens (Human) APLN Polyclonal antibody
-
Uniprot No.:
-
基因名:
-
別名:AGTRL1 ligand antibody; APEL antibody; APEL_HUMAN antibody; Apelin 13 antibody; Apelin-13 antibody; APJ endogenous ligand antibody; Apln antibody; XNPEP2 antibody
-
宿主:Rabbit
-
反應種屬:Human
-
免疫原:Peptide sequence from Human Apelin protein
-
免疫原種屬:Homo sapiens (Human)
-
標記方式:Non-conjugated
-
克隆類型:Polyclonal
-
抗體亞型:IgG
-
純化方式:>95%, Protein G purified
-
濃度:It differs from different batches. Please contact us to confirm it.
-
保存緩沖液:Preservative: 0.03% Proclin 300
Constituents: 50% Glycerol, 0.01M PBS, PH 7.4 -
產(chǎn)品提供形式:Liquid
-
應用范圍:ELISA, IHC
-
推薦稀釋比:
Application Recommended Dilution IHC 1:20-1:200 -
Protocols:
-
儲存條件:Upon receipt, store at -20°C or -80°C. Avoid repeated freeze.
-
貨期:Basically, we can dispatch the products out in 1-3 working days after receiving your orders. Delivery time maybe differs from different purchasing way or location, please kindly consult your local distributors for specific delivery time.
-
用途:For Research Use Only. Not for use in diagnostic or therapeutic procedures.
相關產(chǎn)品
靶點詳情
-
功能:Endogenous ligand for the apelin receptor (APLNR). Drives internalization of the apelin receptor. Apelin-36 dissociates more hardly than (pyroglu)apelin-13 from APLNR. Hormone involved in the regulation of cardiac precursor cell movements during gastrulation and heart morphogenesis. Has an inhibitory effect on cytokine production in response to T-cell receptor/CD3 cross-linking; the oral intake of apelin in the colostrum and the milk might therefore modulate immune responses in neonates. Plays a role in early coronary blood vessels formation. Mediates myocardial contractility in an ERK1/2-dependent manner. May also have a role in the central control of body fluid homeostasis by influencing vasopressin release and drinking behavior.; (Microbial infection) Endogenous ligand for the apelin receptor (APLNR), an alternative coreceptor with CD4 for HIV-1 infection. Inhibits HIV-1 entry in cells coexpressing CD4 and APLNR. Apelin-36 has a greater inhibitory activity on HIV infection than other synthetic apelin derivatives.
-
基因功能參考文獻:
- In hemodialysis patients with pulmonary arterial hypertension, apelin peptide serum levels are significantly lower than patients with normal arterial pressure and this condition is not affected by hemodialysis. PMID: 30087215
- associated with reduced pressure pulsatility in rheumatoid arthritis patients without but not with a high inflammatory burden PMID: 29423718
- Review: apelin has certain therapeutic abilities and can be useful in the treatment of, e.g., insulin resistance, hypertension, etc., but it also can sometimes serve as a negative factor. PMID: 29750964
- In patients with acute obstructive coronary syndrome that had the V103V polymorphism of the APLN gene, they were at greater risk for coronary artery disease. PMID: 28902642
- The aims of this study were to evaluate and correlate circulating chemerin, apelin, vaspin, and omentin-1 levels in obese type 2 diabetic Egyptian patients with coronary artery stenosis (CAS), and to assess their usefulness as noninvasive diagnostic biomarkers. PMID: 28957639
- these observations suggest apelin-APJ signaling in hepatocytes functions to protect against lipid accumulation in liver through two signaling pathways, that is, via AMPK activation and PPARalpha induction. PMID: 28821440
- Studies suggest that apelin/APJ system may be applied to the treatment of cancers by regulating apoptosis, which may play a vital role in anticancer therapy [review]. PMID: 28407045
- miR-497 contributes to oxLDL-induced lipid deposition in macrophages largely via targeting of apelin. PMID: 28653788
- we have identified APLN as putative predictive bvz biomarker in CRC patients. High APLN levels predict a poor response to bvz therapy in CRC. PMID: 28487489
- serum level not associated with increased odds of severe hypertension PMID: 26869250
- Apelin-12 influences troponin I levels in the acute phase of STEMI, whereas during the non-acute phase, low apelin levels were associated with a high rate of MACE. PMID: 28728608
- Apelin concentrations are associated with altered plaque stability mediator levels and atherosclerosis in patients with rheumatoid arthritis. These relations are partially dependent on population origin and systemic inflammatory status. PMID: 28017911
- APLN and APLNR are present in human ovarian cells and APLN increases IGF1-induced steroidogenesis in granulosa cells through an increase in HSD3B protein expression and activation of the MAPK3/1 and Akt pathways. Therefore, APLN and APLNR may play a role in human follicular development and the pathogenesis of PCOS. PMID: 27683264
- Apelin levels mirror the cardiovascular changes seen in pregnancy. Serum and placental apelin levels are decreased in intrauterine growth restriction . PMID: 26880769
- Reduced apelin levels may enhance vasoconstriction to influence high BP and heart's workload in EH and ACS. PMID: 27543713
- Our data suggest that tumor Apelin can be used as a marker to evaluate clinical characteristics and predict prognosis in GC patients. PMID: 27733135
- The apelin/APLNR axis regulates cholangiocarcinoma cell proliferation and tumor angiogenesis. PMID: 27894959
- While plasma apelin increases in obesity, it decreases with increasing age and pubertal stage PMID: 24896245
- Increased plasma concentrations of apelin are associated with ST-segment elevation acute myocardial infarction severity. PMID: 27889567
- Data suggest that the differential expression of Apelin and Apelin receptor APJ yields a "self-generated" gradient mechanisms that accelerates the extension of the sprout. PMID: 27828952
- Postmenopausal breast cancer patients had high levels of apelin and high BMI scores. PMID: 28039702
- For the first time, PRCP is identified as an apelin-cleaving enzyme. PMID: 27449720
- The aim of this study was to evaluate if polymorphisms of APLN and APLNR genes may play a role as susceptibility markers for hypertension in a group of Mexican-Mestizo patients. PMID: 27450650
- serum levels were not statistically different between patients with atrial fibrillation and coronary artery disease PMID: 27776716
- According to this study results, physicians may use initial apelin-12 levels which have a correlation with the disease severity calculated by SYNTAX score to stratify ST-elevation myocardial infarction patients to a high-risk group during hospitalization because of its level as an independent predictor of major adverse coronary event.s PMID: 27770057
- Six-month CT-apelin might be a valuable novel biomarker in identifying non-responders to cardiac resynchronization therapy that was superior to NT-proBNP PMID: 27471876
- high ACE and low apelin preoperatively have roles in CRP and MDA being increased postoperatively, which may be associated with postoperative atrial fibrillation after off pump coronary artery bypass grafting PMID: 28299332
- Single nucleotide polymorphisms of the Apelin gene is associated with diabetes mellitus. PMID: 27831922
- Our results suggest that bisphenol A and its derivatives induce ovarian cancer cell progression by up-regulating apelin, which acts as a mitogenic factor in OVCAR-3 cells. PMID: 28111160
- APLN expression is significantly upregulated in human masticatory mucosa during wound healing PMID: 28005267
- The optimal gene-gene interaction model for both males and females with regard to hypertension was apelin rs3761581-apelin rs3115757-APJ rs7119375. In conclusion, gene polymorphisms of the apelin-APJ system are associated with susceptibility to hypertension. PMID: 27338090
- Lower apelin and higher visfatin plasma levels in high normal blood pressure subjects compared to normal or optimal BP individuals could partially explain the higher cardiovascular risk of the high normal BP group. PMID: 26276791
- apelin 13 levels are elevated in patients with PE. These results suggest that apelin may be a novel biomarker and a potential therapeutic target in patients with acute PE in the future. PMID: 25693918
- Up-regulation of apelin and APJ expression plays an important role in cardioprotection from myocardial ischemia/reperfusion injury. PMID: 27854125
- There was no significant change in plasma apelin levels in acute pulmonary embolism. PMID: 26968282
- The concentrations of gastric peptide(Ghrelin and obestatin)and adipocytokines(omentin and Apelin ) across all subgroups were lower than in the control group. The differences were statistically significant (p < 0.0001), which may be of importance in the development of the disease complications PMID: 26904686
- Resequencing of the apelin gene in subjects stratified by low or high apelin levels identified five APLN variants in an European population. No association was found between the most frequent variant, diabetes, and metabolic parameters. PMID: 26789934
- These findings suggested that Apelin/APLNR signaling may be used as a potential therapeutic target for hypoxic/ischemic injury. PMID: 26676468
- apelin attenuates the osteoblastic differentiation of aortic valve interstitial cells via the ERK and PI3-K/Akt pathway PMID: 26142632
- Genetic variants in the apelin gene are significantly associated with the risk of coronary artery disease in the Turkish population. PMID: 25592107
- Apelin could activate multiple protective mechanisms to prevent heart, brain, liver and kidney ischemia/reperfusion injury. [Review] PMID: 25447414
- Apelin and APLN SNP rs3761581 was associated with combined hypertension with CRAE, indicating that the expression of APLN gene products may be involved in vascular injury. PMID: 25272042
- The expressions of apelin and APJ are significantly augmented by hypoxia through the hypoxia-inducible factor-1 alpha (HIF-1alpha) signaling pathway. PMID: 26436483
- obese (especially diabese) youngsters demonstrated lower serum apelin levels; the G212A polymorphism of the APLNR gene was found to exert a favourable effect on circulating apelin levels in childhood obesity PMID: 25060841
- Apelin directly interferes with thrombin-mediated signaling pathways and platelet activation, secretion, and aggregation, but not with ADP and thromboxane A2-mediated pathways. PMID: 26634301
- apelin is a potential indicator of the vessel normalization window during antiangiogenic therapy. PMID: 26475217
- Mean vaspin and apelin levels were significantly lower in underweight children compared to controls PMID: 25915077
- Treatment with metformin and DPP4 inhibitor vildagliptin favorably changed glycemic indices and apelin levels in type 2 diabetics. PMID: 26316706
- Serum apelin is evelated in new-onset diabetes after transplant, and positively correlate with proteinuria. PMID: 26295182
- apelin13 promoted MCF-7 cell proliferation and invasion via the ERK1/2/AIB1 signaling pathway. PMID: 26135903
顯示更多
收起更多
-
亞細胞定位:Secreted. Secreted, extracellular space.
-
蛋白家族:Apelin family
-
組織特異性:Expressed in the brain with highest levels in the frontal cortex, thalamus, hypothalamus and midbrain. Secreted by the mammary gland into the colostrum and the milk.
-
數(shù)據(jù)庫鏈接:
Most popular with customers
-
-
YWHAB Recombinant Monoclonal Antibody
Applications: ELISA, WB, IHC, IF, FC
Species Reactivity: Human, Mouse, Rat
-
Phospho-YAP1 (S127) Recombinant Monoclonal Antibody
Applications: ELISA, WB, IHC
Species Reactivity: Human
-
-
-
-
-